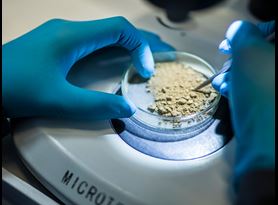

No matter your sector, our experts can help you ensure all aspects of your air quality are compliant with current legislation covering both human health aspects and environmental impacts, including emissions permits with our air quality testing services for stack emissions testing, ambient air quality, indoor air quality, and more.
What Is Air Quality Testing, and Why Is It important?
Air quality testing assesses the air's purity in a specific environment. This typically involves measuring the presence of various pollutants and determining whether the air quality meets regulatory standards. This testing can encompass a wide range of assessments, including stack emissions testing, ambient air quality testing, and indoor air quality testing.
By monitoring and assessing air quality, we can help you identify potential hazards and take necessary actions to maintain or improve air safety. This is crucial for protecting public health and minimizing the impact of air pollution on the environment.
Key Benefits of Air Quality Testing with Element
- Safeguard Public Health: By identifying and monitoring pollutants in the air, air quality testing helps protect the public from the adverse health effects of poor air quality, such as respiratory problems and allergic reactions.
- Meet Regulatory Compliance: Ensure compliance with environmental regulations and avoid potential fines and legal issues.
- Minimise Environmental Impact: By Monitoring air quality with Element, we can help you understand your project's impact on the environment and facilitate proactive measures to reduce pollution.
- Maintain Occupational Safety: safeguard the well-being of your employees or any person on site and maintain a safe and healthy work environment with thorough indoor air quality testing.
Build Trust with Transparent Results
Cut Costs with Well-Maintained Air Quality
Conducting air quality testing can lower expenses by identifying and tackling sources of pollution. This proactive approach helps minimize risks and avoid potential environmental and health-related problems that could lead to expensive clean-up operations or legal issues.
Optimizing ventilation systems according to air quality testing results can help to conserve energy (and spending) by ensuring efficient operation customized to meet your specific air quality requirements.

Andrew Palliser
Element Environmental expert in the Middle East

Our Air Quality Testing Capabilities:
- Bioaerosols Monitoring
- Biogas Engine and Flare Emissions Monitoring
- Biogenic CO2 Emissions Monitoring
- Breathing Air Quality Testing
- Diesel Engine Exhaust Emissions Testing
- Dioxins and Furans Testing
- EN 14181 Calibration
- Energy from Waste Plant Services
Why Choose Element?
Our expert team offers a wide array of air quality testing services for both indoor and outdoor environments. Whether it's analyzing gases, vapors, emissions, ambient air, or ultra-low VOCs, we are here to help you maintain environmental compliance and saftey standards. Element provides ISO 17025 UKAS-MCERTS accredited field-based solutions and ISO 17025 accredited laboratory analysis throughout the UK, Europe, North America, the Middle East, and South Africa. With cutting-edge equipment and a global team of technical experts, we're ready to assist you in achieving environmental and health & safety compliance for air quality.
Contact us today to learn more about our Air quality testing capabilities.
Environmental Testing and Compliance Content
Discover our environmental thought leadership content including articles, white papers, case studies and FAQs.
Written by our industry experts, we explore a range of laboratory and field-based topics related to how we help clients comply with environmental legislation and maintain safe operations.
READ MORERelated Services

Air Dispersion Modeling
Air Dispersion Modeling computes weather patterns and local topography to predict the concentration of emissions at ground level caused by an emissions source. Find out more.

Asbestos Air Testing
Learn about asbestos air testing and ensuring compliance for the requirements of asbestos removal or remediation.

Stack Emissions Testing
Find out how our stack emissions testing services help our customers to prevent exposure, reduce emissions, improve air quality and achieve regulatory compliance for the industrial installations they operate.

Workplace Air Monitoring
Element’s highly experienced team of qualified occupational hygienists specializes in delivering a range of workplace air monitoring services for use within a diverse range of operating environments.
PFAS Testing
Find out how PFOS and PFOA testing with Element's experienced technicians can ensure that you remain compliant with regulatory standards protecting human health and the environment.

Ambient Air Quality Modeling and Dispersion
Find out how we help our customers comply with regulations for ambient air quality and dispersion modeling.

Fugitive Emissions
Find out how we help our customers comply with all relevant UK stack emissions regulations with fugitive emissions monitoring for airborne particulates.

Indoor Air Quality Assessments
Find out how our qualified occupational hygienists can assess indoor air quality looking at chemical, physical, and biological parameters to help our customers comply with regulations.